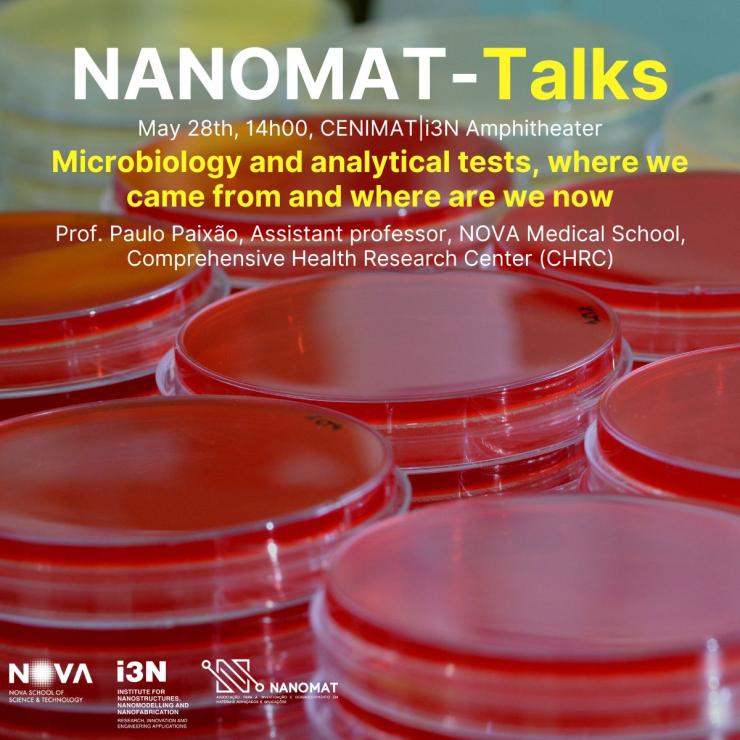
nanomat-talks_10_1

NANOMAT-Talks | Bastonário da Ordem dos Engenheiros
No âmbito do ciclo de seminários NANOMAT-Talks, temos o prazer de convidar toda a comunidade para a sessão “Engenharia na Sociedade“, apresentada pelo Engenheiro Fernando de Almeida Santos, Bastonário da Ordem dos Engenheiros.
O evento terá lugar no dia 12 de maio, pelas 14h30, na prestigiada Sala da Nau, em Sintra.
A entrada é livre, contudo, dada a lotação do espaço, a inscrição é obrigatória através deste formulário.
Uma iniciativa organizada pela Associação NANOMAT, i3N e NOVA FCT, com o apoio da Câmara Municipal de Sintra.
NANOMAT e CM Sintra: Uma visão conjunta para o ecossistema de inovação nacional
No passado dia 26 de fevereiro, a NANOMAT teve o prazer de receber na sua sede, no campus em Caparica, nas instalações do CENIMAT|i3N, uma delegação da Câmara Municipal de Sintra. A reunião foi marcada pela presença da Vereadora Eunice Baeta e de Miguel Ribeiro Martins, Adjunto de Vereação, que se mostraram interessados em ouvir acerca das atividades da nossa Associação e qual o seu foco.
Assim, o encontro teve como principal objetivo apresentar a visão estratégica da NANOMAT e discutir o planeamento de projetos e ações futuras, destinadas a fortalecer o ecossistema de inovação nacional. Durante este encontro foram exploradas diversas vias de colaboração entre as duas entidades, com ênfase nas seguintes áreas:
- Projetos Estratégicos: Foi discutido o alinhamento de objetivos para candidaturas a fundos e iniciativas conjuntas, visando potencializar recursos e expertise para o desenvolvimento de tecnologias inovadoras.
- Divulgação Científica: A NANOMAT partilhou o estado atual dos seus projetos de sensibilização e comunicação, destacando a importância da educação e da divulgação científica para aumentar a conscientização sobre a nanotecnologia e os novos materiais e a importância dos mesmos, como alicerce da prosperidade e crescimento económico.
- Sinergias Regionais: A conversa abordou como a nanotecnologia e os novos materiais podem ter um impacto positivo no tecido empresarial e social do concelho de Sintra, promovendo a inovação e a sustentabilidade nas práticas locais.
Este encontro não só reforça o papel da NANOMAT como um agente de mudança, mas também demonstra o nosso compromisso em colaborar estreitamente com decisores locais. Acreditamos que a transformação do conhecimento científico em valor real para a comunidade é fundamental para o progresso e o desenvolvimento sustentável. Estamos entusiasmados com as possibilidades que esta parceria pode trazer e ansiosos por vê-las materializadas em projetos concretos que beneficiem a região de Sintra e os seus habitantes.
Agradecemos a visita da Câmara Municipal de Sintra e esperamos que este seja apenas o início de uma colaboração frutífera, que contribuirá para um futuro mais inovador e sustentável para todos.
A NANOMAT celebra o seu 3º aniversário!
A NANOMAT celebra 3 anos!
Desde 2022, unimos academia, indústria e regiões para acelerar a ciência, a inovação e a sustentabilidade no domínio dos materiais avançados. Três anos depois, reafirmamos o nosso compromisso com uma economia mais inteligente, resiliente e humana.
Obrigado a todos os associados e parceiros que fazem parte desta jornada!
NANOMAT-Talks 2025